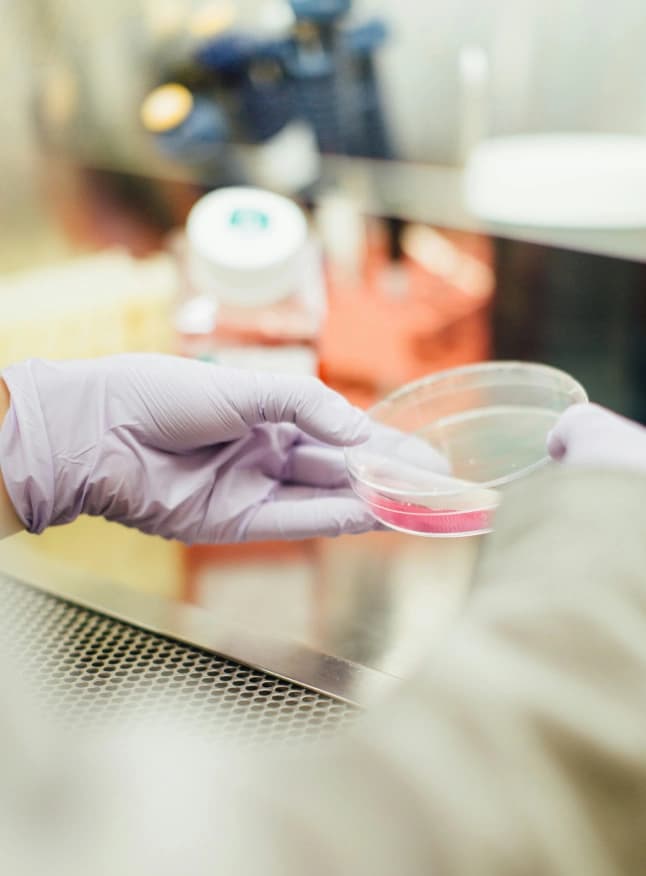
icon

Life Science and Pharma
Accelerating Pharmaceutical Innovation
Streamline research and development, enhance regulatory compliance, and optimize manufacturing. Accelerate innovation and ensure product safety with Lemza's expert solutions.

Transforming Life Sciences and Pharma with Advanced Process Mining Solutions
Accelerate innovation in life sciences and pharma with process mining. Streamline clinical trials, maintain regulatory compliance, and optimize supply chain efficiency. Enhance R&D processes, improve quality control, and optimize manufacturing operations.
Process mining helps identify inefficiencies, reduce time to market, and ensure high-quality products, enabling life sciences and pharmaceutical companies to stay competitive and deliver new treatments faster, improving patient outcomes.
Advancing Life Sciences and Pharma
Our solutions optimize research, development, and production processes, ensuring compliance and accelerating innovation in the life sciences and pharmaceutical industry.
Contact our Experts+4.1x
Boost in drug development process efficiency through process mining from 2020 to 2024 relative to industry standards.
-17%
Reduction in manufacturing costs for pharmaceuticals through the application of process mining from 2019 to 2023.

Use Cases
Accelerated Clinical Trials
Optimizes trial workflows, reducing time to market for new drugs by speeding up patient recruitment and data collection.
Regulatory Compliance
Ensures adherence to regulatory standards through automated monitoring and reporting, reducing the risk of non-compliance.
Supply Chain Efficiency
Improves inventory management and logistics, ensuring timely delivery of products and reducing supply chain costs.
Pharmacovigilance Enhancement
Improve pharmacovigilance processes by leveraging advanced analytics to monitor and analyze adverse event reports. Process mining can help identify patterns and trends in reported side effects, enabling quicker response times and more effective risk management, ultimately ensuring patient safety and regulatory compliance.
Patient Support Programs
Optimize patient support programs by analyzing interactions and outcomes associated with patient assistance services. Process mining can help identify gaps in support, streamline communication with patients, and ensure that patients receive timely and effective assistance with medication adherence, financial aid, and disease management.
Market Access and Pricing Strategy
Enhance market access and pricing strategies by analyzing the processes involved in product launch and market penetration. Process mining can reveal inefficiencies in pricing approvals, reimbursement negotiations, and market introduction, enabling better strategies that ensure quicker and more efficient access to markets, while maximizing revenue potential and compliance with pricing regulations.
R&D Processes
Accelerate research and development activities by streamlining workflows and eliminating inefficiencies. This speeds up product development and helps bring new treatments to market faster.
Quality Control:
Improve quality control processes by identifying and addressing defects and deviations early in the manufacturing process. This ensures high-quality products and reduces the need for costly rework.
Manufacturing Operations
Optimize production processes by using process mining to identify bottlenecks and improve efficiency. This increases output and reduces production costs, enhancing overall operational performance.